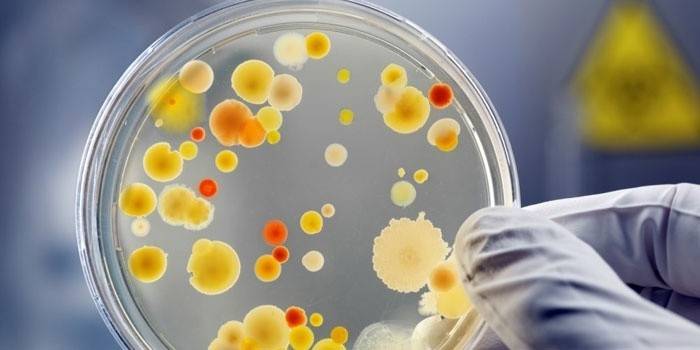

Toxoplazmóza počas tehotenstva - príznaky a testy. Ako sa nakaziť toxoplazmózou počas tehotenstva
Mnoho žien sa obáva nebezpečenstva nakazenia sa toxoplazmózou počas života plodu dieťaťa. Neznalosť zásad životného cyklu parazita spôsobuje, že sa tehotné ženy zbavia svojich obľúbených domácich miláčikov, aby sa predišlo invázii. Nasledujúce informácie vám pomôžu pochopiť opodstatnenie takýchto akcií.
Čo je toxoplazmóza?
Príčinou vývoja choroby sú jednoduché organizmy. Primárna infekcia toxoplazmou počas tehotenstva môže mať pre dieťa veľa vážnych následkov. Parazit je schopný tlmiť nervový systém plodu, čo vyvoláva výskyt závažných malformácií. Z tohto dôvodu sú budúce matky často znepokojené otázkou, či sú toxoplazmóza a tehotenstvo kompatibilné. Odborníci sa domnievajú, že opakovaná infekcia žiadnym spôsobom neovplyvňuje stav dieťaťa.
Je dôležité si uvedomiť, že toxoplazmóza patrí do skupiny infekcií horákov, ktoré sa môžu aktivovať u ženy počas vývoja plodu. Táto schopnosť patogénov vyplýva z fyziologického zníženia imunity u tehotnej ženy. V tejto súvislosti by pred plánovaním počatia dieťaťa mala nastávajúca matka zodpovedne liečiť tento problém a odovzdať analýzu toxoplazmózy.
Aké je nebezpečenstvo infekcie mačkami počas tehotenstva
Niektoré účinky napadnutia parazitmi počas tehotenstva už boli spomenuté. Je dôležité si uvedomiť, že aj pri primárnej infekcii ženy toxoplazmózou počas tehotenstva sú riziká invázie plodu nízke. V treťom semestri je pravdepodobnosť infekcie asi 60%. V skorších termínoch je tento ukazovateľ ešte nižší, ale ak k parazitickej invázii došlo pred 24 týždňami, nezostáva nič ako ukončiť tehotenstvo kvôli závažnosti klinických príznakov choroby. Ďalej sa pozorujú nasledujúce účinky vrodenej toxoplazmózy:
- Medzi skoré prejavy choroby možno identifikovať:
- intrauterinná retardácia rastu;
- hydrocefalus;
- nedostatočné rozvinutie lebky a mozgu;
- intrakraniálne kalcifikácie;
- hepatitída A;
- chorioretinitída;
- trombocytopénia;
- hepatosplenomegália.
- Neskoré prejavy toxoplazmózy sa nazývajú mentálne poruchy, epileptické záchvaty.
Toxoplazma a tehotenstvo - spôsoby infekcie
Predpokladá sa, že nosičmi parazitických chorôb sú domáce zvieratá: mačky, psy, hlodavce. Mali by ste vedieť, že toxoplazmóza počas tehotenstva sa dá získať nielen konzumáciou mäsa z infikovaných zvierat. Pri nedostatočnom tepelnom ošetrení potravy parazit preniká do ľudského tela - sprostredkujúceho hostiteľa, kde sa na istý čas pripravuje na následnú inváziu.
Konečným bodom zastavenia toxoplazmy je mačka, v ktorej má patogén príležitosť množiť sa. Je dôležité spomenúť, že cysty parazitov sa šíria spolu s pouličným prachom a časticami zeme. Vo vonkajšom prostredí je infekcia schopná zostať aktívna niekoľko rokov. Okrem toho môže dôjsť k prenosu toxoplazmózy v dôsledku:
- jesť mäso bez riadneho tepelného spracovania;
- ľudský kontakt s predmetmi kontaminovanými trusmi mačiek;
- transplacentálna infekcia toxoplazmózou počas tehotenstva;
- nedodržiavanie jednoduchých pravidiel osobnej hygieny.
Príznaky toxoplazmózy u tehotných žien
Pri infikovaní sú parazitárne cysty doslova postihnuté všetky orgány a systémy ľudského tela. Z tohto dôvodu je ochorenie charakterizované polymorfnými symptómami. Ako odpovedajú na bežnú otázku žien, ako sa prejavuje toxoplazmóza u tehotných žien, odborníci varujú, že invázia je charakterizovaná skrytým klinickým obrazom. V zriedkavých prípadoch je to bolesť hlavy, nevoľnosť. Akútna forma choroby je charakteristická pre jedincov so zníženou obranyschopnosťou tela. Medzitým sa môže vyskytnúť toxoplazmóza počas tehotenstva:
- vysoká horúčka;
- slabosť;
- bolesť hlavy;
- strata chuti do jedla;
- ospalosť;
- kožné vyrážky;
- očné patológie;
- zväčšená pečeň, slezina, lymfatické uzliny;
- zápal pľúc;
- príznaky poškodenia centrálneho nervového systému;
- duševné poruchy.
Diagnóza choroby
Toxoplazmóza sa zisťuje prostredníctvom špecifických laboratórnych a inštrumentálnych štúdií. V tomto prípade sa používajú sérologické diagnostické metódy. V prípade, že je choroba asymptomatická, je ťažšie ju odhaliť. Platí to najmä pre skryté a chronické formy poškodenia. Infekciu ľudí toxoplazmózou možno zistiť:
- Laboratórne testy:
- ELISA (enzýmová imunotest);
- RNIF (nepriame imunofluorescenčné reakcie);
- CSC (reakcie viazania komplementu);
- PCR (polymerázová reťazová reakcia).
- Inštrumentálne prostredníctvom:
- Röntgenové lúče;
- diagnostika oka;
- biopsia lymfatických uzlín.

ELISA na toxoplazmózu počas tehotenstva
Enzýmový imunotest nie je povinný a predpisuje sa, ak existuje osobitná indikácia. Analýza toxoplazmózy u tehotných žien sa vykonáva, ak budúca matka zistí príznaky choroby. Metóda ELISA určuje prítomnosť protilátok triedy IgM a IgG v ženskej krvi. Imunoglobulíny M sa v tele syntetizujú v prvých dňoch infekcie toxoplazmózou a po 3 až 12 mesiacoch úplne vymiznú z biologickej tekutiny, na rozdiel od protilátok triedy G, ktoré sa naopak začínajú intenzívne produkovať a uchovávať na celý život.
Malo by sa tiež poznamenať, že avidita alebo schopnosť receptorov na povrchu imunitných buniek viazať sa na parazitárny antigén za účelom jeho ďalšieho zničenia, hrá veľkú úlohu pri tvorbe ochrannej bariéry proti toxoplazmóze. Spravidla sa v prvých štádiách infekcie pozoruje nízka avidita. Normálne, ako sa vytvára humorálna reakcia, počet imunoglobulínov G sa významne zvyšuje.
Dešifrovanie analýzy na toxoplazmózu
Pozitívne výsledky laboratórnych testov počas tehotenstva možno interpretovať rôznymi spôsobmi. Ako už bolo uvedené, primárna infekcia v období embryonálneho vývoja dieťaťa ohrozuje život plodu. Ak sa v krvi zistia protilátky proti toxoplazmóze počas tehotenstva, prognóza bude závisieť od triedy a počtu detegovaných imunoglobulínov.
Najlepšou možnosťou je prítomnosť budúcej matky B-lymfocytov s receptorom G v krvi, čo naznačuje prítomnosť imunity proti infekcii. Mnoho žien sa obáva otázky, čo robiť, ak sa nenájdu protilátky proti toxoplazme. S týmto vývojom udalostí by budúce matky mali vynaložiť všetko úsilie, aby sa pred koncom tehotenstva neinfikovali. Stáva sa, že v krvi sú detegované obe triedy protilátok. Tento výsledok analýzy naznačuje, že infekcia nastala asi pred rokom.

Liečba toxoplazmózy u tehotných žien
Je dôležité pochopiť, že je nemožné zbaviť sa parazita úplne. Liečbou infekcie je obvyklé chápať jej prechod na chronickú formu. Akákoľvek imunitná fluktuácia v tele, ktorá sa pozoruje aj počas tehotenstva, môže vyvolať zhoršenie toxoplazmózy. Z tohto dôvodu je chorobe ľahšie predchádzať ako sa vyrovnať s jej negatívnymi dôsledkami. Prevencia spočíva spravidla v dodržiavaní jednoduchých pravidiel osobnej hygieny.
Skutočnou zárukou ochrany pred toxoplazmózou je napriek tomu len silná imunita, ktorá sa u nastávajúcich matiek znižuje z fyziologických dôvodov. Vo väčšine prípadov nie je možné liečiť tehotné ženy. Liečba liekom je indikovaná iba v druhom trimestri. Pri závažných formách infekcie lekári často odporúčajú ukončiť tehotenstvo. Liečba akútnej toxoplazmózy zahŕňa vymenovanie nasledujúcich liekov:
- pyrimetamín;
- sulfónamidy;
- spiramycín;
- Kyselina listová.
Video: toxoplazmóza pre tehotné ženy
Toxoplazmóza - škola Dr. Komarovského
recenzia
Elena, 35 rokov Toxoplazmóza bola chorá asi pred 2 rokmi počas tehotenstva, čo malo najnegatívnejšie účinky na dieťa. Zdá sa, že si vždy umyla ruky, nedržala mačky v dome, ale túto infekciu zachytila. Po 2 liečebných cykloch bol v transkripte analýzy stále preukázaná prítomnosť akútnej formy toxoplazmózy, takže bolo rozhodnuté ukončiť tehotenstvo.
Olga, 28 rokov Z malého mačiatka som si od suseda mačky vybral toxoplazmu. Až do otehotnenia neboli pozorované žiadne príznaky. Obrany tela začali prechádzať a toxoplazmóza „kvetla“. Od druhého semestra som začal brať lieky, ktoré spôsobovali veľa vedľajších účinkov. Žiaľ, tehotenstvo nebolo možné zachrániť.